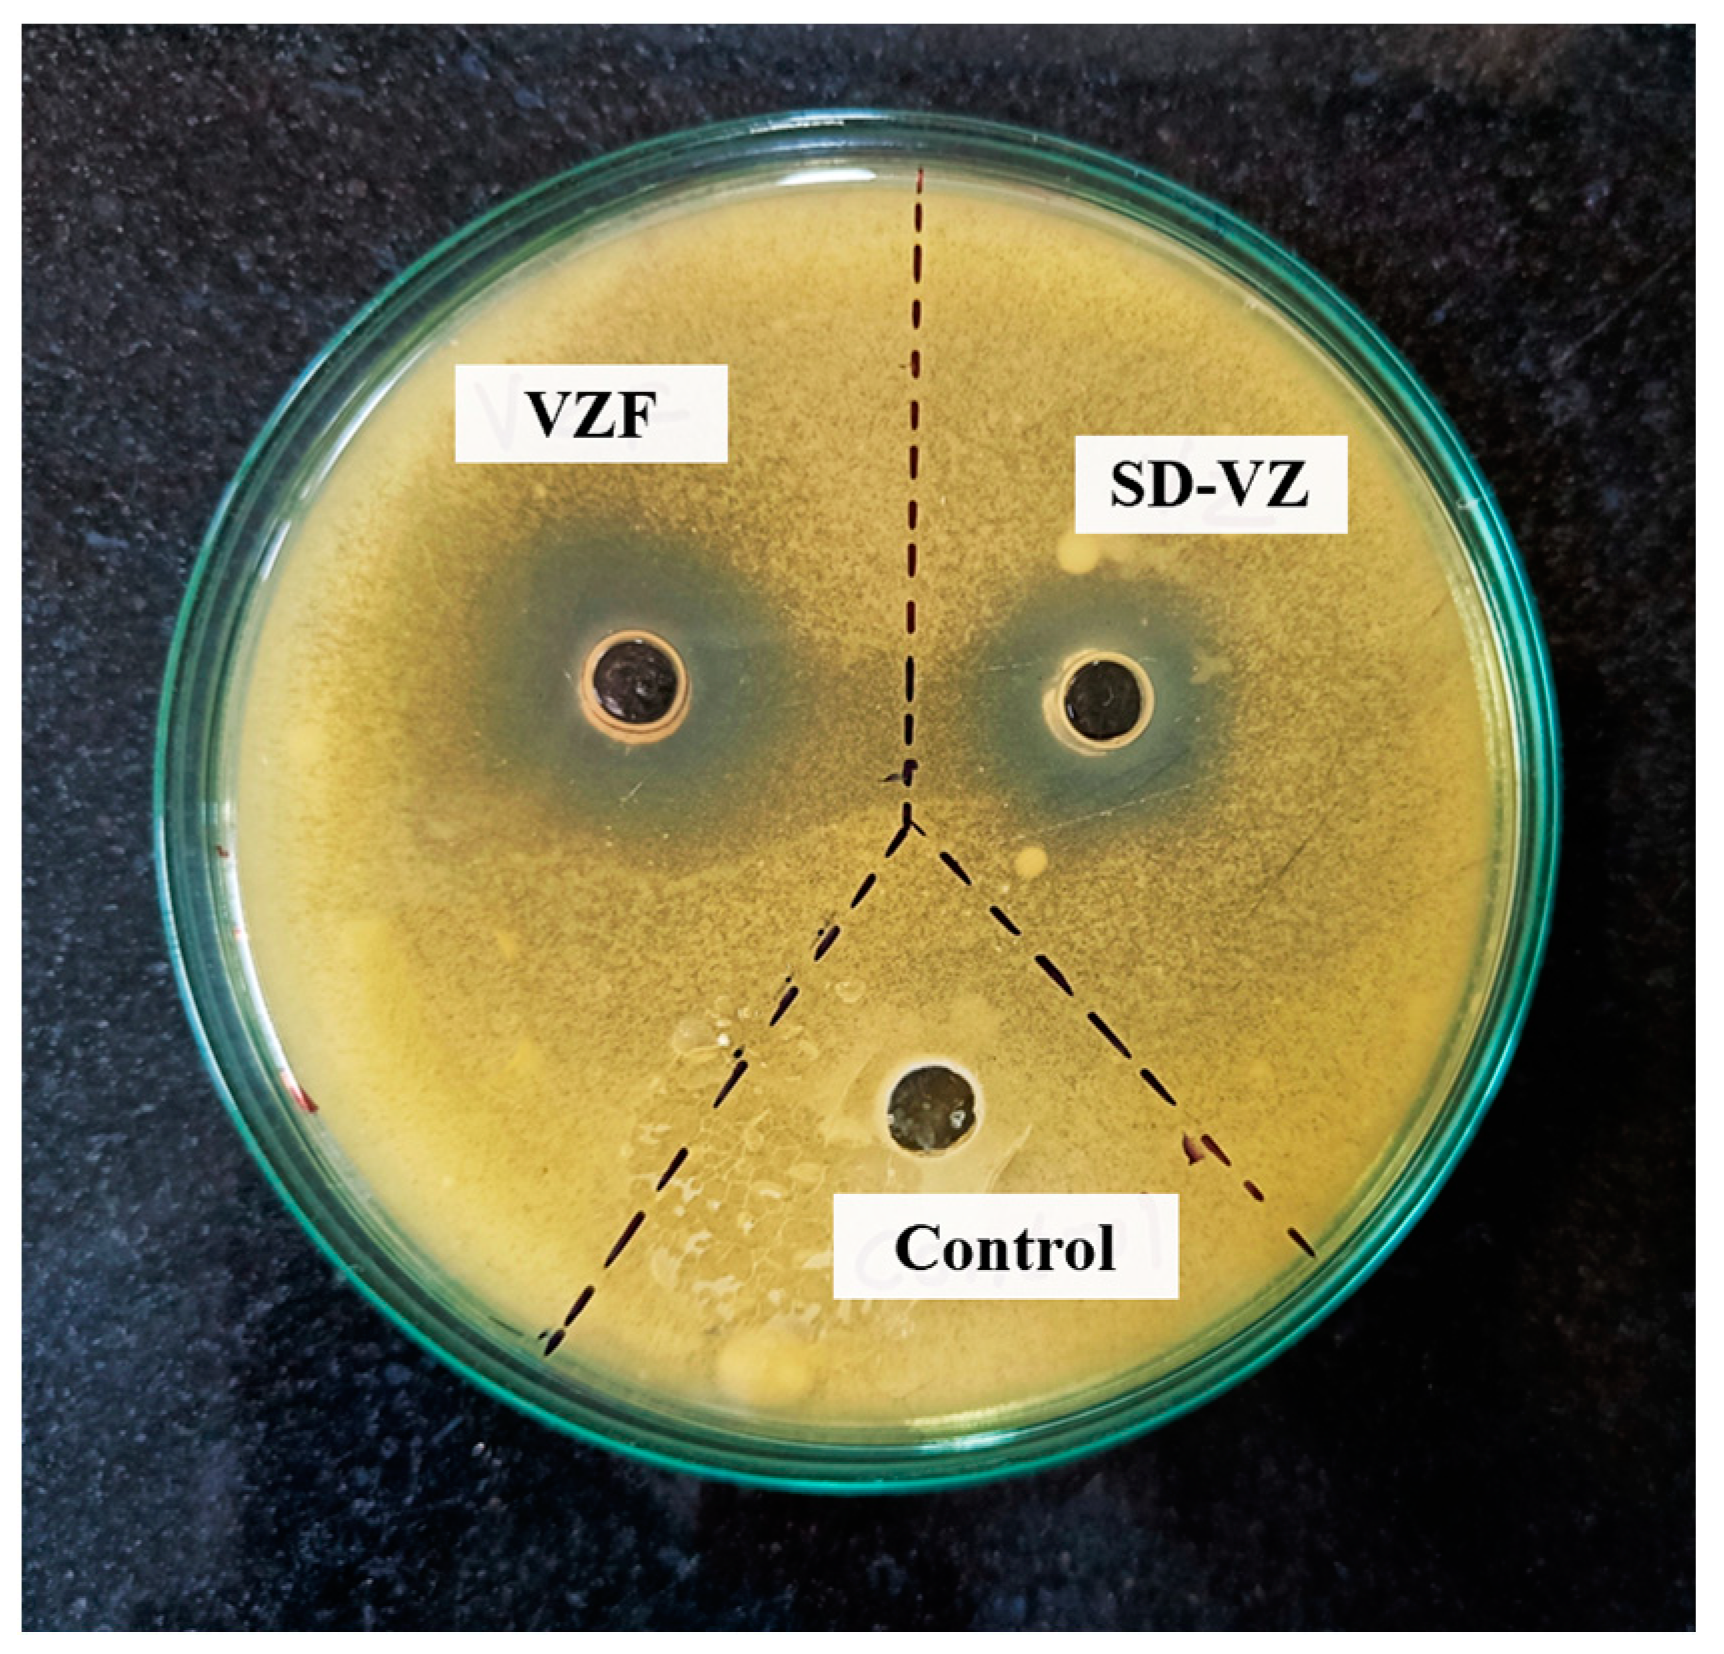
Pharmaceutics 17 00622 g012 Pharmaceutics 17 00622 g012

Development of Voriconazole Proliposome Based Dry Powder for Inhalation: A Design of Experiment Approach
Abstract
1. Introduction
2. Materials and Methods
2.1. Production of VZ Proliposome Formulation (VZF) Based DPI by Spray Drying Method
2.2. Screening Design
2.3. Optimization Design
2.4. Characterization of DPI Formulation
2.4.1. Vesicle Size
2.4.2. Percent Entrapment Efficiency (%EE)
2.4.3. Micromeritic Properties
The Angle of Repose
Bulk Density and Tapped Density
2.4.4. Morphology by Field Emission Scanning Electron Microscopy (FESEM)
2.4.5. Fourier-Transform Infrared Red Spectroscopy (FTIR)
2.4.6. Differential Scanning Calorimetry (DSC) Study
2.4.7. X-ray Diffraction (XRD) Analysis
2.4.8. In Vitro Drug Release
2.4.9. Laser Diffraction Study of Powder
2.4.10. In Vitro Aerosol Performance
2.4.11. In Vitro Antifungal Activity
2.4.12. In Vivo Lung Retention Study
3. Result and Discussion
3.1. Formulation and Screening of Proliposome DPI
3.2. Optimization Using Face-Centered Central Composite Design
3.2.1. Effect on Vesicle Size
3.2.2. Effect on Entrapment Efficiency
3.2.3. Effect on Drug Release
3.3. FESEM Analysis
3.4. Fourier-Transform Infrared Red Spectroscopy
3.5. DSC Analysis
3.6. XRD Analysis
3.7. Drug Release and Drug Release Kinetics
3.8. Laser Diffraction Study of Powder
3.9. In Vitro Aerosol Performance
3.10. Antifungal Activity
3.11. In Vivo Lung Retention Study
4. Conclusions
Author Contributions
Funding
Institutional Review Board Statement
Informed Consent Statement
Data Availability Statement
Conflicts of Interest
References
- Kousha, M.; Tadi, R.; Soubani, A.O. Pulmonary Aspergillosis: A Clinical Review. Eur. Respir. Rev. 2011, 20, 156–174. [Google Scholar] [CrossRef]
- Olum, R.; Baluku, J.B.; Kazibwe, A.; Russell, L.; Bongomin, F. Tolerability of Oral Itraconazole and Voriconazole for the Treatment of Chronic Pulmonary Aspergillosis: A Systematic Review and Meta-Analysis. PLoS ONE 2020, 15, e0240374. [Google Scholar] [CrossRef]
- Bongomin, F.; Gago, S.; Oladele, R.O.; Denning, D.W. Global and Multi-National Prevalence of Fungal Diseases—Estimate Precision. J. Fungi 2017, 3, 57. [Google Scholar] [CrossRef]
- van der Torre, M.H.; Shen, H.; Rautemaa-Richardson, R.; Richardson, M.D.; Novak-Frazer, L. Molecular Epidemiology of Aspergillus fumigatus in Chronic Pulmonary Aspergillosis Patients. J. Fungi 2021, 7, 152. [Google Scholar] [CrossRef]
- Baddley, J.W. Clinical Risk Factors for Invasive Aspergillosis. Med. Mycol. 2011, 49, 7–12. [Google Scholar] [CrossRef]
- van der Linden, J.W.M.; Arendrup, M.C.; Warris, A.; Lagrou, K.; Pelloux, H.; Hauser, P.M.; Chryssanthou, E.; Mellado, E.; Kidd, S.E.; Tortorano, A.M.; et al. Prospective Multicenter International Surveillance of Azole Resistance in Aspergillus fumigatus. Emerg. Infect. Dis. 2015, 21, 1041–1044. [Google Scholar] [CrossRef]
- Barac, A.; Kosmidis, C.; Alastruey-Izquierdo, A.; Salzer, H.J.F. Chronic Pulmonary Aspergillosis Update: A Year in Review. Med. Mycol. 2019, 57, S104–S109. [Google Scholar] [CrossRef]
- Denning, D.W.; Pleuvry, A.; Cole, D.C. Global Burden of Chronic Pulmonary Aspergillosis Complicating Sarcoidosis. Eur. Respir. J. 2013, 41, 621–626. [Google Scholar] [CrossRef]
- Crum-Cianflone, N.F. Invasive Aspergillosis Associated with Severe Influenza Infections. Open Forum Infect. Dis. 2016, 3, ofw171. [Google Scholar] [CrossRef]
- Hayes, G.; Novak-Frazer, L. Chronic Pulmonary Aspergillosis—Where Are We? And Where Are We Going? J. Fungi 2016, 2, 18. [Google Scholar] [CrossRef]
- Thompson, G.R.; Patterson, T.F. Pulmonary Aspergillosis: Recent Advances. Semin. Respir. Crit. Care Med. 2011, 32, 673–681. [Google Scholar] [CrossRef]
- Pearson, M.M.; Rogers, P.D.; Cleary, J.D.; Chapman, S.W. Voriconazole: A New Triazole Antifungal Agent. Ann. Pharmacother. 2003, 37, 420–432. [Google Scholar] [CrossRef] [PubMed]
- Voriconazole. Available online: https://go.drugbank.com/drugs/DB00582 (accessed on 17 December 2023).
- Malani, A.N.; Kerr, L.E.; Kauffman, C.A. Voriconazole: How to Use This Antifungal Agent and What to Expect. Semin. Respir. Crit. Care Med. 2015, 36, 786–795. [Google Scholar] [CrossRef] [PubMed]
- Niwa, T.; Imagawa, Y.; Yamazaki, H. Drug Interactions between Nine Antifungal Agents and Drugs Metabolized by Human Cytochromes P450. Curr. Drug Metab. 2015, 15, 651–679. [Google Scholar] [CrossRef] [PubMed]
- Warrilow, A.G.S.; Martel, C.M.; Parker, J.E.; Melo, N.; Lamb, D.C.; Nes, W.D.; Kelly, D.E.; Kelly, S.L. Azole Binding Properties of Candida Albicans Sterol 14-α Demethylase (CaCYP51). Antimicrob. Agents Chemother. 2010, 54, 4235–4245. [Google Scholar] [CrossRef]
- Dolton, M.J.; McLachlan, A.J. Voriconazole Pharmacokinetics and Exposure–Response Relationships: Assessing the Links between Exposure, Efficacy and Toxicity. Int. J. Antimicrob. Agents 2014, 44, 183–193. [Google Scholar] [CrossRef]
- Li, X.; Frechen, S.; Moj, D.; Lehr, T.; Taubert, M.; Hsin, C.; Mikus, G.; Neuvonen, P.J.; Olkkola, K.T.; Saari, T.I.; et al. A Physiologically Based Pharmacokinetic Model of Voriconazole Integrating Time-Dependent Inhibition of CYP3A4, Genetic Polymorphisms of CYP2C19 and Predictions of Drug–Drug Interactions. Clin. Pharmacokinet. 2020, 59, 781–808. [Google Scholar] [CrossRef]
- Tanaka, R.; Eto, D.; Goto, K.; Ohchi, Y.; Yasuda, N.; Suzuki, Y.; Tatsuta, R.; Kitano, T.; Itoh, H. Pharmacokinetic and Adsorptive Analyses of Administration of Oral Voriconazole Suspension via Enteral Feeding Tube in Intensive Care Unit Patients. Biol. Pharm. Bull. 2021, 44, 737–741. [Google Scholar] [CrossRef]
- Greer, N.D. Voriconazole: The Newest Triazole Antifungal Agent. Bayl. Univ. Med. Cent. Proc. 2003, 16, 241–248. [Google Scholar] [CrossRef]
- Patterson, T.F.; Thompson, G.R.; Denning, D.W.; Fishman, J.A.; Hadley, S.; Herbrecht, R.; Kontoyiannis, D.P.; Marr, K.A.; Morrison, V.A.; Nguyen, M.H.; et al. Executive Summary: Practice Guidelines for the Diagnosis and Management of Aspergillosis: 2016 Update by the Infectious Diseases Society of America. Clin. Infect. Dis. 2016, 63, 433–442. [Google Scholar] [CrossRef]
- Den Hollander, J.G.; van Arkel, C.; Rijnders, B.J.; Lugtenburg, P.J.; de Marie, S.; Levin, M.-D. Incidence of Voriconazole Hepatotoxicity during Intravenous and Oral Treatment for Invasive Fungal Infections. J. Antimicrob. Chemother. 2006, 57, 1248–1250. [Google Scholar] [CrossRef] [PubMed]
- Levin, M.-D.; den Hollander, J.G.; van der Holt, B.; Rijnders, B.J.; van Vliet, M.; Sonneveld, P.; van Schaik, R.H.N. Hepatotoxicity of Oral and Intravenous Voriconazole in Relation to Cytochrome P450 Polymorphisms. J. Antimicrob. Chemother. 2007, 60, 1104–1107. [Google Scholar] [CrossRef] [PubMed]
- Maertens, J.; Theunissen, K.; Boogaerts, M. Invasive Aspergillosis: Focus on New Approaches and New Therapeutic Agents. Curr. Med. Chem. Anti-Infect. Agents 2005, 1, 65–81. [Google Scholar] [CrossRef]
- Merlos, R.; Amighi, K.; Wauthoz, N. Recent Developments in Inhaled Triazoles Against Invasive Pulmonary Aspergillosis. Curr. Fungal Infect. Rep. 2014, 8, 331–342. [Google Scholar] [CrossRef]
- Mumtaz, T.; Ahmed, N.; ul Hassan, N.; Badshah, M.; Khan, S.; ur Rehman, A. Voriconazole Nanoparticles-Based Film Forming Spray: An Efficient Approach for Potential Treatment of Topical Fungal Infections. J. Drug Deliv. Sci. Technol. 2022, 70, 102973. [Google Scholar] [CrossRef]
- Callard Preedy, E.; Prokopovich, P. 4—Novel Coatings and Biotechnology Trends in Inhaler Devices. In Inhaler Devices; Prokopovich, P., Ed.; Woodhead Publishing Series in Biomaterials; Woodhead Publishing: Sawston, UK, 2013; pp. 37–50. ISBN 978-0-85709-496-4. [Google Scholar]
- Arora, S.; Haghi, M.; Young, P.M.; Kappl, M.; Traini, D.; Jain, S. Highly Respirable Dry Powder Inhalable Formulation of Voriconazole with Enhanced Pulmonary Bioavailability. Expert Opin. Drug Deliv. 2016, 13, 183–193. [Google Scholar] [CrossRef]
- Das, P.J.; Paul, P.; Mukherjee, B.; Mazumder, B.; Mondal, L.; Baishya, R.; Debnath, M.C.; Dey, K.S. Pulmonary Delivery of Voriconazole Loaded Nanoparticles Providing a Prolonged Drug Level in Lungs: A Promise for Treating Fungal Infection. Mol. Pharm. 2015, 12, 2651–2664. [Google Scholar] [CrossRef]
- Sinha, B.; Mukherjee, B.; Pattnaik, G. Poly-Lactide-Co-Glycolide Nanoparticles Containing Voriconazole for Pulmonary Delivery: In vitro and In vivo Study. Nanomed. Nanotechnol. Biol. Med. 2013, 9, 94–104. [Google Scholar] [CrossRef]
- Arora, S.; Haghi, M.; Loo, C.Y.; Traini, D.; Young, P.M.; Jain, S. Development of an Inhaled Controlled Release Voriconazole Dry Powder Formulation for the Treatment of Respiratory Fungal Infection. Mol. Pharm. 2015, 12, 2001–2009. [Google Scholar] [CrossRef]
- Beinborn, N.A.; Du, J.; Wiederhold, N.P.; Smyth, H.D.C.; Williams, R.O. Dry Powder Insufflation of Crystalline and Amorphous Voriconazole Formulations Produced by Thin Film Freezing to Mice. Eur. J. Pharm. Biopharm. 2012, 81, 600–608. [Google Scholar] [CrossRef]
- Rundfeldt, C.; Steckel, H.; Scherliess, H.; Wyska, E.; Wlaź, P. Inhalable Highly Concentrated Itraconazole Nanosuspension for the Treatment of Bronchopulmonary Aspergillosis. Eur. J. Pharm. Biopharm. 2013, 83, 44–53. [Google Scholar] [CrossRef]
- Yang, W.; Chow, K.T.; Lang, B.; Wiederhold, N.P.; Johnston, K.P.; Williams, R.O. In vitro Characterization and Pharmacokinetics in Mice Following Pulmonary Delivery of Itraconazole as Cyclodextrin Solubilized Solution. Eur. J. Pharm. Sci. 2010, 39, 336–347. [Google Scholar] [CrossRef]
- Khare, A.; Singh, I.; Pawar, P.; Grover, K. Design and Evaluation of Voriconazole Loaded Solid Lipid Nanoparticles for Ophthalmic Application. J. Drug Deliv. 2016, 2016, 659036. [Google Scholar] [CrossRef]
- Schiffelers, R.; Storm, G.; Bakker-Woudenberg, I. Liposome-Encapsulated Aminoglycosides in Pre-Clinical and Clinical Studies. J. Antimicrob. Chemother. 2001, 48, 333–344. [Google Scholar] [CrossRef] [PubMed]
- Wang, S.; Ye, T.; Yang, B.; Yi, X.; Yao, H. 7-Ethyl-10-Hydroxycamptothecin Proliposomes with a Novel Preparation Method: Optimized Formulation, Characterization and in-Vivo Evaluation. Drug Dev. Ind. Pharm. 2013, 39, 393–401. [Google Scholar] [CrossRef] [PubMed]
- Ye, T.; Sun, S.; Sugianto, T.D.; Tang, P.; Parumasivam, T.; Chang, Y.K.; Astudillo, A.; Wang, S.; Chan, H.K. Novel Combination Proliposomes Containing Tobramycin and Clarithromycin Effective against Pseudomonas Aeruginosa Biofilms. Int. J. Pharm. 2018, 552, 130–138. [Google Scholar] [CrossRef] [PubMed]
- Payne, N.I.; Ambrose, C.V.; Timmins, P.; Ward, M.D.; Ridgway, F. Proliposomes: A Novel Solution to an Old Problem. J. Pharm. Sci. 1986, 75, 325–329. [Google Scholar] [CrossRef] [PubMed]
- Adel, I.M.; ElMeligy, M.F.; Abdelrahim, M.E.A.; Maged, A.; Abdelkhalek, A.A.; Abdelmoteleb, A.M.M.; Elkasabgy, N.A. Design and Characterization of Spray-Dried Proliposomes for the Pulmonary Delivery of Curcumin. Int. J. Nanomed. 2021, 16, 2667–2687. [Google Scholar] [CrossRef]
- Broadhead, J.; Rouan, S.K.E.; Hau, I.; Rhodes, C.T. The Effect of Process and Formulation Variables on the Properties of Spray-Dried β-Galactosidase. J. Pharm. Pharmacol. 1994, 46, 458–467. [Google Scholar] [CrossRef]
- Patel, R.P.; Suthar, M.P.P. and A.M. Spray Drying Technology: An Overview. Indian J. Sci. Technol. 2009, 2, 44–47. [Google Scholar] [CrossRef]
- Beck-Broichsitter, M.; Schweiger, C.; Schmehl, T.; Gessler, T.; Seeger, W.; Kissel, T. Characterization of Novel Spray-Dried Polymeric Particles for Controlled Pulmonary Drug Delivery. J. Control. Release 2012, 158, 329–335. [Google Scholar] [CrossRef]
- Patil-Gadhe, A.; Pokharkar, V. Single Step Spray Drying Method to Develop Proliposomes for Inhalation: A Systematic Study Based on Quality by Design Approach. Pulm. Pharmacol. Ther. 2014, 27, 197–207. [Google Scholar] [CrossRef]
- Rojanarat, W.; Nakpheng, T.; Thawithong, E.; Yanyium, N.; Srichana, T. Inhaled Pyrazinamide Proliposome for Targeting Alveolar Macrophages. Drug Deliv. 2012, 19, 334–345. [Google Scholar] [CrossRef] [PubMed]
- Rojanarat, W.; Changsan, N.; Tawithong, E.; Pinsuwan, S.; Chan, H.K.; Srichana, T. Isoniazid Proliposome Powders for Inhalation-Preparation, Characterization and Cell Culture Studies. Int. J. Mol. Sci. 2011, 12, 4414–4434. [Google Scholar] [CrossRef] [PubMed]
- Chaurasiya, B.; Zhao, Y.-Y. Dry Powder for Pulmonary Delivery: A Comprehensive Review. Pharmaceutics 2021, 13, 31. [Google Scholar] [CrossRef]
- Mohan, A.R.; Wang, Q.; Dhapare, S.; Bielski, E.; Kaviratna, A.; Han, L.; Boc, S.; Newman, B. Advancements in the Design and Development of Dry Powder Inhalers and Potential Implications for Generic Development. Pharmaceutics 2022, 14, 2495. [Google Scholar] [CrossRef] [PubMed]
- Sallam, A. Design of Experiments for the Development of Inhalational Products. In Design of Experiments for Pharmaceutical Product Development; Springer: Singapore, 2021; pp. 97–115. ISBN 978-981-334-350-4. [Google Scholar]
- Pasteka, R.; Schöllbauer, L.A.; Santos da Costa, J.P.; Kolar, R.; Forjan, M. Experimental Evaluation of Dry Powder Inhalers during Inhalation and Exhalation Using a Model of the Human Respiratory System (xPULMTM). Pharmaceutics 2022, 14, 500. [Google Scholar] [CrossRef] [PubMed]
- Zhao, Y.; Xiao, C.; Hou, J.; Wu, J.; Xiao, Y.; Zhang, B.; Sandaradura, I.; Yan, M. A Large Sample Retrospective Study on the Distinction of Voriconazole Concentration in Asian Patients from Different Clinical Departments. Pharmaceuticals 2021, 14, 1239. [Google Scholar] [CrossRef] [PubMed]
- Lankalapalli, S.; Vemuri, V.D.; Tenneti, V.S.V.K.; Guntaka, P.R. Bioavailability Enhancement of Voriconazole Using Liposomal Pastilles: Formulation and Experimental Design Investigation. J. Liposome Res. 2022, 32, 293–307. [Google Scholar] [CrossRef] [PubMed]
- Tiwari, S.; Mistry, P.; Patel, V. SLNs Based on Co-Processed Lipids for Topical Delivery of Terbinafine Hydrochloride. J. Pharm. Drug Dev. 2014, 2, 404. [Google Scholar] [CrossRef][Green Version]
- Deshkar, S.S.; Bhalerao, S.G.; Jadhav, M.S.; Shirolkar, S.V. Formulation and Optimization of Topical Solid Lipid Nanoparticles Based Gel of Dapsone Using Design of Experiment. Pharm. Nanotechnol. 2018, 6, 264–275. [Google Scholar] [CrossRef]
- Le, V.N.P.; Thi, T.H.H.; Robins, E.; Flament, M.P. Dry Powder Inhalers: Study of the Parameters Influencing Adhesion and Dispersion of Fluticasone Propionate. AAPS PharmSciTech 2012, 13, 477–484. [Google Scholar] [CrossRef]
- Rudén, J.; Frenning, G.; Bramer, T.; Thalberg, K.; Alderborn, G. On the Relationship between Blend State and Dispersibility of Adhesive Mixtures Containing Active Pharmaceutical Ingredients. Int. J. Pharm. X 2021, 3, 100069. [Google Scholar] [CrossRef]
- Balouiri, M.; Sadiki, M.; Ibnsouda, S.K. Methods for In vitro Evaluating Antimicrobial Activity: A Review. J. Pharm. Anal. 2016, 6, 71–79. [Google Scholar] [CrossRef] [PubMed]
- Valgas, C.; de Souza, S.M.; Smânia, E.F.A.; Smânia, A., Jr. Screening Methods to Determine Antibacterial Activity of Natural Products. Braz. J. Microbiol. 2007, 38, 369–380. [Google Scholar] [CrossRef]
- Magaldi, S.; Mata-Essayag, S.; Hartung de Capriles, C.; Perez, C.; Colella, M.T.; Olaizola, C.; Ontiveros, Y. Well Diffusion for Antifungal Susceptibility Testing. Int. J. Infect. Dis. 2004, 8, 39–45. [Google Scholar] [CrossRef] [PubMed]
- Kim, Y.; Park, E.J.; Kim, T.; Na, D.H. Recent Progress in Drug Release Testing Methods of Biopolymeric Particulate System. Pharmaceutics 2021, 13, 1313. [Google Scholar] [CrossRef] [PubMed]
- Deshkar, S.S.; Palve, V.K. Formulation and Development of Thermosensitive Cyclodextrin-Based in Situ Gel of Voriconazole for Vaginal Delivery. J. Drug Deliv. Sci. Technol. 2019, 49, 277–285. [Google Scholar] [CrossRef]
- Nadarassan, D.K.; Assi, K.H.; Chrystyn, H. Aerodynamic Characteristics of a Dry Powder Inhaler at Low Inhalation Flows Using a Mixing Inlet with an Andersen Cascade Impactor. Eur. J. Pharm. Sci. 2010, 39, 348–354. [Google Scholar] [CrossRef] [PubMed]
- Feige-Diller, J.; Krakenberg, V.; Bierbaum, L.; Seifert, L.; Palme, R.; Kaiser, S.; Sachser, N.; Richter, S.H. The Effects of Different Feeding Routines on Welfare in Laboratory Mice. Front. Vet. Sci. 2020, 6, 479. [Google Scholar] [CrossRef] [PubMed]
- Alhajj, N.; O’Reilly, N.J.; Cathcart, H. Leucine as an Excipient in Spray Dried Powder for Inhalation. Drug Discov. Today 2021, 26, 2384–2396. [Google Scholar] [CrossRef]
- Lähde, A.; Raula, J.; Kauppinen, E.I. Production of L-Leucine Nanoparticles under Various Conditions Using an Aerosol Flow Reactor Method. J. Nanomater. 2008, 2008, e680897. [Google Scholar] [CrossRef]
- Sibum, I.; Hagedoorn, P.; Kluitman, M.P.G.; Kloezen, M.; Frijlink, H.W.; Grasmeijer, F. Dispersibility and Storage Stability Optimization of High Dose Isoniazid Dry Powder Inhalation Formulations with L-Leucine or Trileucine. Pharmaceutics 2020, 12, 24. [Google Scholar] [CrossRef] [PubMed]
- Bhattacharya, S. Central Composite Design for Response Surface Methodology and Its Application in Pharmacy. In Response Surface Methodology in Engineering Science; IntechOpen: London, UK, 2021; ISBN 978-1-83968-918-5. [Google Scholar]
- Lisik, A.; Musiał, W. Conductomeric Evaluation of the Release Kinetics of Active Substances from Pharmaceutical Preparations Containing Iron Ions. Materials 2019, 12, 730. [Google Scholar] [CrossRef] [PubMed]
- Baggi, R.B.; Kilaru, N.B. Calculation of Predominant Drug Release Mechanism Using Peppas-Sahlin Model, Part-I (Substitution Method): A Linear Regression Approach. Asian J. Pharm. Technol. 2016, 6, 223–230. [Google Scholar] [CrossRef]
- Fayyaz, H.A.; EL-Massik, M.A.; Bahey-El-Din, M.; Abdel-Bary, A.; Abdallah, O.Y.; Eltaher, H.M. Targeted DPPC/DMPG Surface-Modified Voriconazole Lipid Nanoparticles Control Invasive Pulmonary Aspergillosis in Immunocompromised Population: In-Vitro and in-Vivo Assessment. Int. J. Pharm. 2024, 649, 123663. [Google Scholar] [CrossRef] [PubMed]
- Sheth, P.; Stein, S.W.; Myrdal, P.B. Factors Influencing Aerodynamic Particle Size Distribution of Suspension Pressurized Metered Dose Inhalers. AAPS PharmSciTech 2014, 16, 192–201. [Google Scholar] [CrossRef] [PubMed]
- Miyamoto, K.; Taga, H.; Akita, T.; Yamashita, C. Simple Method to Measure the Aerodynamic Size Distribution of Porous Particles Generated on Lyophilizate for Dry Powder Inhalation. Pharmaceutics 2020, 12, 976. [Google Scholar] [CrossRef]
- Costa, P.; Sousa Lobo, J.M. Modeling and Comparison of Dissolution Profiles. Eur. J. Pharm. Sci. 2001, 13, 123–133. [Google Scholar] [CrossRef] [PubMed]
- Costa, P.; Lobo, J. Evaluation of Mathematical Models Describing Drug Release from Estradiol Transdermal Systems. Drug Dev. Ind. Pharm. 2003, 29, 89–97. [Google Scholar] [CrossRef]
- Ghosh, A.; Chakraborty, P. Formulation and Mathematical Optimization of Controlled Release Calcium Alginate Micro Pellets of Frusemide. Biomed. Res. Int. 2013, 2013, 819674. [Google Scholar] [CrossRef] [PubMed]
- Cepuritis, R.; Garboczi, E.J.; Ferraris, C.F.; Jacobsen, S.; Sørensen, B.E. Measurement of Particle Size Distribution and Specific Surface Area for Crushed Concrete Aggregate Fines. Adv. Powder Technol. 2017, 28, 706–720. [Google Scholar] [CrossRef]
- Hackley, V.A.; Lum, L.-S.; Gintautas, V.; Ferraris, C.F. Particle Size Analysis by Laser Diffraction Spectrometry: Application to Cementitious Powders; NISTIR 7097; National Institute of Standards and Technology: Gaithersburg, MD, USA, 2004. [Google Scholar]
- DECHRAKSA, J.; SUWANDECHA, T.; SRICHANA, T. Deposition Pattern of Polydisperse Dry Powders in Andersen Cascade Impactor—Aerodynamic Assessment for Inhalation Experimentally and In Silico. Turk. J. Pharm. Sci. 2020, 17, 20–26. [Google Scholar] [CrossRef] [PubMed]

| RUN | Factors | |||
|---|---|---|---|---|
| Lipid:Drug (A) | Phospholipon 90H:Cholesterol (B) | Amount of Carrier (mg) (C) | Spray Rate (mL/min) (D) | |
| S-1 | 1 (4:1) | −1 (1:1) | −1 (500) | 1 (4) |
| S-2 | −1 (1:1) | −1 (1:1) | 1 (2500) | 1 (4) |
| S-3 | −1 (1:1) | −1 (1:1) | −1 (500) | −1 (2) |
| S-4 | −1 (1:1) | 1 (1:4) | −1 (500) | 1 (4) |
| S-5 | 1 (4:1) | −1 (1:1) | 1 (2500) | −1 (2) |
| S-6 | −1 (1:1) | 1 (1:4) | 1 (2500) | −1 (2) |
| S-7 | 1 (4:1) | 1 (1:4) | 1 (2500) | 1 (4) |
| S-8 | 1 (4:1) | 1 (1:4) | −1 (500) | −1 (2) |
| BATCH | X1 (Lipid:Drug Mass Ratio) | X2 (Amount of Carrier in mg) | Vesicle Size (nm) * Y1 | PDI * | Entrapment Efficiency (%) * Y2 | Drug Release in 8 h (%) * Y3 |
|---|---|---|---|---|---|---|
| F-1 | 3:1(+1) | 1500 | 174.7 | 0.377 | 62.87 ± 0.3 | 101.2 ± 0.9 |
| F-2 | 2:1(0) | 1500 | 177.9 | 0.400 | 72.48 ± 0.7 | 95.3 ± 0.7 |
| F-3 | 2:1(0) | 500 | 371.0 | 0.288 | 86.42 ± 0.2 | 97.1 |
| F-4 | 2:1(0) | 2500 | 294.2 | 0.300 | 68.43 ± 1.0 | 101.3 ± 0.2 |
| F-5 | 2:1(0) | 1500 | 191.7 | 0.328 | 72.94 ± 0.6 | 82.0 ± 0.1 |
| F-6 | 3:1(+1) | 2500 | 175.2 | 0.339 | 54.77 ± 0.5 | 100.2 ± 0.8 |
| F-7 | 1:1(−1) | 1500 | 164.8 | 0.348 | 59.05 ± 0.2 | 58.8 ± 1.0 |
| F-8 | 1:1(−1) | 2500 | 242.9 | 0.267 | 74.71 ± 0.3 | 64.7 ± 0.6 |
| F-9 | 2:1(0) | 1500 | 204.7 | 0.376 | 71.91 ± 0.2 | 82.6 ± 0.9 |
| F-10 | 3:1(+1) | 500 | 170.7 | 0.363 | 78.46 ± 0.6 | 97.1 ± 0.4 |
| F-11 | 1:1(−1) | 500 | 281.9 | 0.421 | 90.52 ± 0.3 | 57.9 ± 0.1 |
| F-12 | 2:1(0) | 1500 | 191.4 | 0.330 ± 0.97 | 72.44 | 86.6 ± 0.2 |
| F-13 | 2:1(0) | 1500 | 182 | 0.352 | 72.0 ± 0.2 | 82.3 ± 0.8 |
| Source | Sum of Squares | Mean of Square | F Value | p-Value (Prob > F) | ||||
|---|---|---|---|---|---|---|---|---|
| Y1 | Y2 | Y1 | Y2 | Y1 | Y2 | Y1 | Y2 | |
| Model | 2.408 × 105 | 1088.38 | 1.204 × 105 | 544.19 | 6.43 | 24.72 | 0.0415 | 0.0026 |
| A | - | 782.10 | - | 782.10 | - | 35.53 | - | 0.0019 |
| B | 1.195 × 105 | - | 1.195 × 105 | - | 6.38 | - | 0.0528 | - |
| C | 1.213 × 105 | 306.28 | 1.213 × 105 | 306.28 | 6.47 | 13.91 | 0.0516 | 0.0136 |
| Source | F Value | p-Value (Prob > F) | ||||
|---|---|---|---|---|---|---|
| Y1 | Y2 | Y3 | Y1 | Y2 | Y3 | |
| Model | 4.52 | 7.79 | 14.57 | 0.0367 | 0.0089 | 0.0014 |
| X1- Lipid:Drug | 2.99 | 4.96 | 60.31 | 0.1274 | 0.0613 | 0.0001 |
| X2- Amt. of Carrier | 1.30 | 22.47 | 1.36 | 0.2923 | 0.0021 | 0.2819 |
| X1X2 | 0.30 | 0.50 | 0.019 | 0.6026 | 0.5035 | 0.8948 |
| X12 | 7.49 | 5.91 | 10.50 | 0.0290 | 0.0453 | 0.0142 |
| X22 | 16.37 | 9.11 | 3.94 | 0.0049 | 0.0194 | 0.0876 |
| Code | Zero-Order | First Order | Matrix | Korsemeyer–Peppas | Hixson Crowell | ||
|---|---|---|---|---|---|---|---|
| R2 | R2 | R2 | K | R2 | n | R2 | |
| SD-VZ | 0.9290 | 0.9339 | 0.9941 | 2.0478 | 0.9965 | 0.6368 | 0.9323 |
| PD-VZ | 0.9403 | 0.9446 | 0.9921 | 1.9771 | 0.9961 | 0.6683 | 0.9432 |
| VZF | 0.9949 | 0.9855 | 0.9507 | 1.2597 | 0.9931 | 1.0372 | 0.9953 |
| Stage | Cut-Off Diameter (μm) | Drug Retained (mg) | Fraction Retained | % Fraction Retained | % Cumulative (More than) | % Cumulative (Less than) | |||||
|---|---|---|---|---|---|---|---|---|---|---|---|
| SD-VZ | VZF (F5) | SD-VZ | VZF (F5) | SD-VZ | VZF (F5) | SD-VZ | VZF (F5) | SD-VZ | VZF (F5) | ||
| E Cap | - | 1.73 | 1.99 | 0.03 | 0.04 | 3.56 | 4.08 | - | - | - | - |
| Device | - | 4.85 | 4.81 | 0.01 | 0.10 | 10.00 | 9.85 | - | - | - | - |
| Pre-Separator | - | 17.72 | 6.32 | 0.36 | 0.12 | 36.56 | 12.94 | - | - | - | - |
| Ind-Port | - | 6.38 | 4.01 | 0.13 | 0.08 | 13.15 | 8.21 | - | - | - | - |
| S0 | 9 | 8.21 | 1.93 | 0.47 | 0.06 | 46.10 | 6.04 | 46.10 | 6.04 | 53.91 | 93.97 |
| S1 | 5.8 | 3.37 | 2.99 | 0.19 | 0.09 | 18.94 | 9.36 | 65.04 | 15.40 | 34.96 | 84.61 |
| S2 | 4.7 | 1.82 | 4.87 | 0.10 | 0.15 | 10.25 | 15.33 | 75.29 | 30.73 | 24.71 | 69.28 |
| S3 | 3.3 | 1.61 | 11.47 | 0.09 | 0.36 | 9.01 | 36.24 | 84.30 | 66.97 | 15.70 | 33.04 |
| S4 | 2.1 | 0.78 | 8.54 | 0.04 | 0.26 | 4.40 | 26.99 | 88.69 | 93.96 | 11.31 | 6.05 |
| S5 | 1.1 | 0.56 | 0.38 | 0.03 | 0.01 | 3.13 | 1.18 | 91.82 | 95.15 | 8.18 | 4.86 |
| S6 | 0.7 | 0.61 | 0.55 | 0.03 | 0.02 | 3.47 | 1.73 | 95.30 | 96.88 | 4.70 | 3.13 |
| S7 | 0.4 | 0.59 | 0.40 | 0.03 | 0.01 | 3.31 | 1.25 | 98.61 | 98.12 | 1.39 | 1.89 |
| Filter | - | 0.25 | 0.61 | 0.01 | 0.02 | 1.41 | 1.89 | 100.02 | 100.02 | ||
| Parameter | SD-VZ | VZF (F5) |
|---|---|---|
| Mass Median Aerodynamic Diameter (MMAD) (μm) | 8.35 ± 0.23 | 3.85 ± 0.15 |
| Fine Particle Fraction (FPF) (<4.7 μm) | 12.82 ± 0.18 | 54.86 ± 0.05 |
| % Emitted Dose (ED) | 86.43 ± 0.13 | 86.07 ± 0.13 |
| Lung Pharmacokinetic Parameters | Oral Dispersion (OD-VZ) | SD-VZ Inhalation | VZF Inhalation |
|---|---|---|---|
| Cmax (μg·g−1) | 34.20 ± 22.96 | 161.45 ± 11.19 | 286.95 ± 5.67 |
| AUC0–24h (μg·g−1·h) | 417.81 | 1010.898 | 3924.845 |
| AUC0–inf h (μg·g−1·h) | 698.38 | 1107.723 | 6702.645 |
Disclaimer/Publisher’s Note: The statements, opinions and data contained in all publications are solely those of the individual author(s) and contributor(s) and not of MDPI and/or the editor(s). MDPI and/or the editor(s) disclaim responsibility for any injury to people or property resulting from any ideas, methods, instructions or products referred to in the content. |
© 2025 by the authors. Licensee MDPI, Basel, Switzerland. This article is an open access article distributed under the terms and conditions of the Creative Commons Attribution (CC BY) license (https://creativecommons.org/licenses/by/4.0/).
Share and Cite
Deshkar, S.; Vas, A.; Pagar, R.; Giram, P.; Thomas, A.; Undale, V. Development of Voriconazole Proliposome Based Dry Powder for Inhalation: A Design of Experiment Approach. Pharmaceutics 2025, 17, 622. https://doi.org/10.3390/pharmaceutics17050622
Deshkar S, Vas A, Pagar R, Giram P, Thomas A, Undale V. Development of Voriconazole Proliposome Based Dry Powder for Inhalation: A Design of Experiment Approach. Pharmaceutics. 2025; 17(5):622. https://doi.org/10.3390/pharmaceutics17050622
Chicago/Turabian StyleDeshkar, Sanjeevani, Alisha Vas, Roshani Pagar, Prabhanjan Giram, Asha Thomas, and Vaishali Undale. 2025. "Development of Voriconazole Proliposome Based Dry Powder for Inhalation: A Design of Experiment Approach" Pharmaceutics 17, no. 5: 622. https://doi.org/10.3390/pharmaceutics17050622
APA StyleDeshkar, S., Vas, A., Pagar, R., Giram, P., Thomas, A., & Undale, V. (2025). Development of Voriconazole Proliposome Based Dry Powder for Inhalation: A Design of Experiment Approach. Pharmaceutics, 17(5), 622. https://doi.org/10.3390/pharmaceutics17050622

